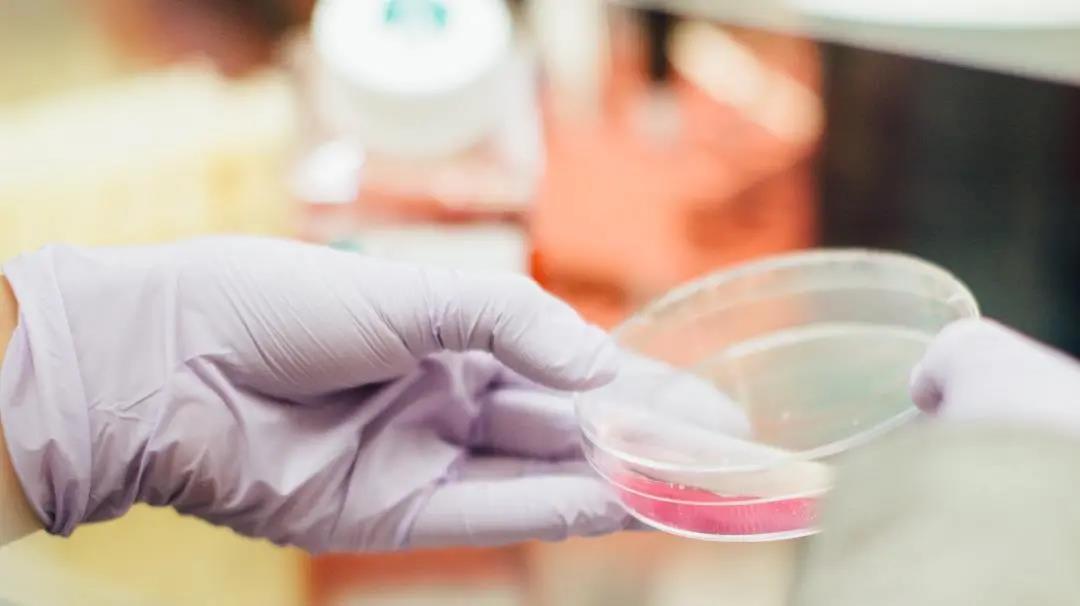
这些年，常用的癌症检测方式有哪些？

肿瘤治疗哪些基因检测不必做

肿瘤治疗领域里的基因检测,简单来讲,就是用测序技术来看看肿瘤细胞的基因组和正常细胞的基因组有哪些不一样。这些不一样的地方,我们称之为“基因突变”。发生在关键基因(...

肿瘤治疗领域里的基因检测,简单来讲,就是用测序技术来看看肿瘤细胞的基因组和正常细胞的基因组有哪些不一样。这些不一样的地方,我们称之为“基因突变”。发生在关键基因(...
肿瘤筛查是早期发现癌症和癌前病变的重要途径。目前,肿瘤筛查的方式主要有以下几个方法:影像学检查▶ X线检查。▶ 超声检查:包括A型、 B型超声波检查。▶...

一般来说,癌症治疗对早期诊断出的癌症更为有效,但许多癌症早筛手段目前并不充分,多家生物公司目前正致力于开发与癌症早筛相关的血液检测,通过确定血液中与癌细胞相关的生...